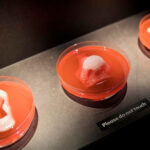
The Dawn Of A New Era Of Regenerative Medicine: Tissue Engineering Comes Of Age The Dawn Of A New Era Of Regenerative Medicine: Tissue Engineering Comes Of Age

By Amy Marturana Winderl – HealthCentral –
A look at the next-gen therapies that hope to turn the field of medicine—and treating age-related chronic conditions—upside down.
Taking a person’s own cells out of their body and then putting them back in to heal damaged organs and tissues is a medical concept that feels plucked straight out of a science fiction book. It’s even trippier to consider taking a different person’s cells or lab-grown organs and nestling them into your own body to treat or cure a disease. Yet this concept—regenerative medicine—is something scientists have actually been working on IRL for years.